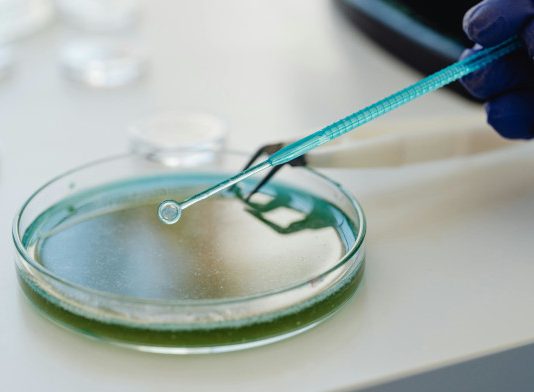
El Gobierno aprueba un real decreto para garantizar un alto nivel de protección en productos sanitarios de diagnóstico ‘in vitro’

Un vecino de Alicante recupera más de 6.000€ por gastos hipotecarios abusivos
Unive Abogados logra otra victoria en la reclamación de gastos hipotecarios. El Juzgado de Primera Instancia nº5 de Alicante ha confirmado la abusividad y...
Invertir en innovación: el camino para hacer del Legaltech un verdadero aliado de la...
La igualdad real entre hombres y mujeres en todos los ámbitos profesionales y en concreto en la abogacía, sigue siendo una quimera. El informe...
El Gobierno da vía libre a subir el sueldo de los funcionarios un 2,5%...
En el sector público estatal, la subida del 2,5% se hará efectiva en una nómina adicional este mes y afectará a 540.000 empleados públicos
El...
Fundación Aranzadi LA LEY e Inkietos lanzan la 11ª edición del Legal Management Forum
Tendrá lugar los próximos 14 y 15 de octubre en la sede de Banco Santander España (itinerarios paralelos) y en el Auditorio Mutua Madrileña...
El TS establece que la reinversión de la venta de un inmueble en otra...
La Sala estima el recurso de una contribuyente y anula la liquidación que le giró Hacienda en 2012, por importe de 41.255 euros, de...
Evolución de la mujer en posiciones de Dirección: Compliance
Percibo una evolución muy positiva de la igualdad en el mundo de derecho entre hombres y mujeres, quizás no suficiente, pero en cualquier caso...
La Justicia Europea admite los recursos de las asociaciones ecologistas contra los fabricantes de...
Un programa informático con el que van equipados una serie de vehículos diésel, que reduce la eficacia del sistema de control de las emisiones...
La Segunda Oportunidad, una ley que funciona a pesar de ser una gran desconocida
El 1º Congreso Europeo sobre Segunda Oportunidad se ha cerrado con la conclusión de que la Ley de Segunda Oportunidad “funciona”, como muestran los...
La Abogacía emplaza al Senado a agilizar la reforma de la pasarela para los...
La Mesa de la Comisión de Justicia de la Cámara Alta ha visitado hoy el Consejo General para estrechar la colaboración de ambas instituciones
El...
Salvador González toma posesión como nuevo presidente del Consejo General de la Abogacía
Salvador González Martín ha tomado este viernes posesión como nuevo presidente de la Abogacía Española reclamando un mayor protagonismo social para la abogacía, un...